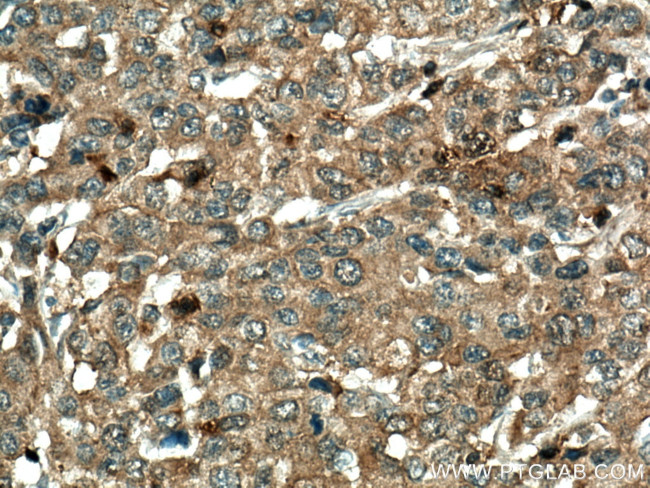
RGS5 Antibody in Immunohistochemistry (Paraffin) (IHC (P))

Search
Proteintech
RGS5 Polyclonal Antibody
{{$productOrderCtrl.translations['antibody.pdp.commerceCard.promotion.promotions']}}
{{$productOrderCtrl.translations['antibody.pdp.commerceCard.promotion.viewpromo']}}
{{$productOrderCtrl.translations['antibody.pdp.commerceCard.promotion.promocode']}}: {{promo.promoCode}} {{promo.promoTitle}} {{promo.promoDescription}}. {{$productOrderCtrl.translations['antibody.pdp.commerceCard.promotion.learnmore']}}
产品信息
11590-1-AP
种属反应
宿主/亚型
分类
类型
抗原
偶联物
形式
浓度
规格
纯化类型
保存液
内含物
保存条件
运输条件
产品详细信息
The 42 kDa band recognized by this antibody is a RGS5-RGS5 dimer.
Immunogen sequence: MCKGLAALP HSCLERAKEI KIKLGILLQK PDSVGDLVIP YNEKPEKPAK TQKTSLDEAL QWRDSLDKLL QNNYGLASFK SFLKSEFSEE NLEFWIACED YKKIKSPAKM AEKAKQIYEE FIQTEAPKEV NIDHFTKDIT MKNLVEPSLS SFDMAQKRIH ALMEKDSLPR FVRSEFYQEL IK (1-181 aa encoded by BC030059)
靶标信息
The regulator of G protein signaling (RGS) proteins are signal transduction molecules that have structural homology to SST2 of Saccharomyces cerevisiae and EGL-10 of Caenorhabditis elegans. Multiple genes homologous to SST2 are present in higher eukaryotes. RGS proteins are involved in the regulation of heterotrimeric G proteins by acting as GTPase activators. The mRNA of the human gene is abundantly expressed in heart, lung, skeletal muscle, and small intestine, and at low levels in brain, placenta, liver, colon, and leukocytes.
仅用于科研。不用于诊断过程。未经明确授权不得转售。
生物信息学
蛋白别名: regulator of G protein signaling; regulator of G protein signaling 5; Regulator of G-protein signaling 5; regulator of G-protein signalling 5; RGS-5; RGS5; RP11-430G6.2; unnamed protein product
基因别名: 1110070A02Rik; MST092; MST106; MST129; MSTP032; MSTP092; MSTP106; MSTP129; RGS5
UniProt ID: (Human) O15539, (Mouse) O08850, (Rat) P49800
Entrez Gene ID: (Human) 8490, (Mouse) 19737, (Rat) 54294